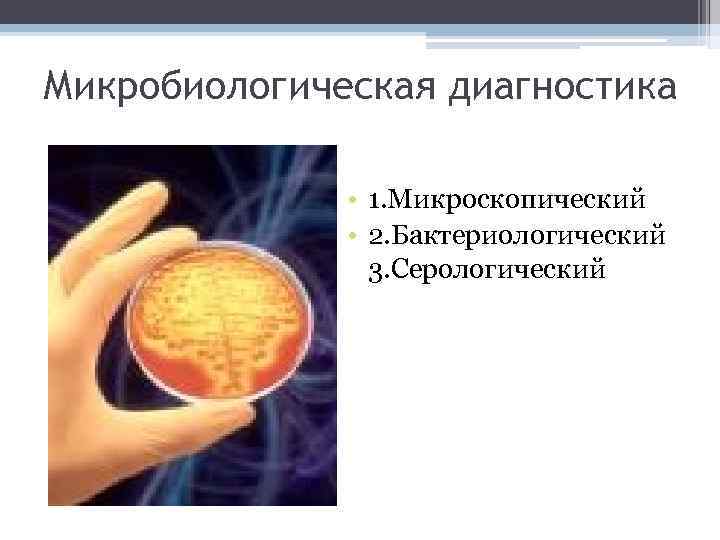
Микробиологическая диагностика • 1. Микроскопический • 2. Бактериологический 3. Серологический

Презентация ИЭ 2003-новая версия.ppt
- Количество слайдов: 20
 Инфекционный эндокардит
Инфекционный эндокардит
 Инфекционный эндокардит • воспалительное поражение клапанов сердца и пристеночного эндокарда, обусловленное прямым внедрением возбудителя и протекающее чаще всего по типу сепсиса, с циркуляцией возбудителя в крови, эмболиями, иммунопатологическими изменениями и осложнениями.
Инфекционный эндокардит • воспалительное поражение клапанов сердца и пристеночного эндокарда, обусловленное прямым внедрением возбудителя и протекающее чаще всего по типу сепсиса, с циркуляцией возбудителя в крови, эмболиями, иммунопатологическими изменениями и осложнениями.
 История: • 16 век- первые данные о септическом эндокардите • 19 век- детальное изучение заболевания • 1856 год- Вирхов подробно описал язвенный эндокардит у больных сепсисом • Впервые воспроизвести ИЭ в эксперименте удалось Розенбаху • Ильинский, Паронианц в России описали первичный и вторичный ИЭ • 1885 год- Ослер описал клинику ИЭ • 20 век- Либман, Крылов, Горяев исследовали ИЭ по этиологии, патогенезу, клинике
История: • 16 век- первые данные о септическом эндокардите • 19 век- детальное изучение заболевания • 1856 год- Вирхов подробно описал язвенный эндокардит у больных сепсисом • Впервые воспроизвести ИЭ в эксперименте удалось Розенбаху • Ильинский, Паронианц в России описали первичный и вторичный ИЭ • 1885 год- Ослер описал клинику ИЭ • 20 век- Либман, Крылов, Горяев исследовали ИЭ по этиологии, патогенезу, клинике
 Этиология современного инфекционного эндокардита • Срептококки (55%) ▫ 35% - зеленящие стрептококки ▫ 10% - энтерококки группы D ▫ 10% - другие стрептококки • Стафилококки (35%) • Другие (10%): ▫ HACEK (Haemophilus, Actinomyces, Cardiobacterium, Eikenella, Kingella), псевдомонады, Гр-бактерии кишечной группы, пневмококки • Культурально-негативный ИЭ (5 -15%): ▫ Предшествующее применение АБ ▫ Грибки требующие специальных методов культивирования ▫ Coxiella burnetii, Chlamidia sp. , Legionella sp, Mycoplasma sp
Этиология современного инфекционного эндокардита • Срептококки (55%) ▫ 35% - зеленящие стрептококки ▫ 10% - энтерококки группы D ▫ 10% - другие стрептококки • Стафилококки (35%) • Другие (10%): ▫ HACEK (Haemophilus, Actinomyces, Cardiobacterium, Eikenella, Kingella), псевдомонады, Гр-бактерии кишечной группы, пневмококки • Культурально-негативный ИЭ (5 -15%): ▫ Предшествующее применение АБ ▫ Грибки требующие специальных методов культивирования ▫ Coxiella burnetii, Chlamidia sp. , Legionella sp, Mycoplasma sp
 Род Streptococcus • Распространенные виды: S. pyogenes, S. A, S. B
Род Streptococcus • Распространенные виды: S. pyogenes, S. A, S. B
 Poд Staphylococcus • Основными возбудителями ИЭ являются S. aureus, S. epidermidis, S. saprophyticus.
Poд Staphylococcus • Основными возбудителями ИЭ являются S. aureus, S. epidermidis, S. saprophyticus.
 Семейство Enterobacteriaceae • Условно-патогенные МО родов: Escherichia, Salmonella, Shigella, Klebsiela, Yersinia
Семейство Enterobacteriaceae • Условно-патогенные МО родов: Escherichia, Salmonella, Shigella, Klebsiela, Yersinia
 Candida
Candida
 Aspirgillus fumigatus
Aspirgillus fumigatus
 Распространенность: • 50%-аортальный клапан • 15%-митральный клапан • 25 -30%-аортальный и митральный клапаны • 5%-другие клапаны
Распространенность: • 50%-аортальный клапан • 15%-митральный клапан • 25 -30%-аортальный и митральный клапаны • 5%-другие клапаны
 Патогенез • Врождённые, приобрётенные дефекты клапанов сердца • Увеличение скорости, появление турбулентности трансклапанного потока крови • Механическое повреждение эндотелия клапанов • Отложение тромбоцитов и фибрина на повреждённых участках эндокарда • Формирование хронического неинфекционного эндокардита с тромботическими вегетациями • Преходящая бактериемия на фоне снижения реактивности организма • Адгезия и колонизация патогенных бактерий в фибрино-тромбоцитарных вегетациях • Воспаление эндокарда, формирование микробных вегетаций, разрушение клапанов • Формирование сердечной недостаточности, системного инфекционного процесса с эмболическим, тромбогеморрагическим, иммунокомплексным поражением внутренних органов и тканей
Патогенез • Врождённые, приобрётенные дефекты клапанов сердца • Увеличение скорости, появление турбулентности трансклапанного потока крови • Механическое повреждение эндотелия клапанов • Отложение тромбоцитов и фибрина на повреждённых участках эндокарда • Формирование хронического неинфекционного эндокардита с тромботическими вегетациями • Преходящая бактериемия на фоне снижения реактивности организма • Адгезия и колонизация патогенных бактерий в фибрино-тромбоцитарных вегетациях • Воспаление эндокарда, формирование микробных вегетаций, разрушение клапанов • Формирование сердечной недостаточности, системного инфекционного процесса с эмболическим, тромбогеморрагическим, иммунокомплексным поражением внутренних органов и тканей
 Органы-мишени: поражения • Кожа: Абсцесс Узелки Пурпура • Сердце: Абсцесс Миокардит Перикардит Инфаркт • Нервная система: Абсцесс Менинго-энцефалит Киста • Сосуды: Васкулит Аневризма Тромбоз Геморрагии • Лёгкие: Абсцесс Пневмония Плеврит Инфаркт Эмпиема • Почки: Абсцесс Нефрит Инфаркт Острая почечная недостаточность • Печень: Абсцесс Гепатит Инфаркт • Селезёнка: Спленомегалия Абсцесс Инфаркт
Органы-мишени: поражения • Кожа: Абсцесс Узелки Пурпура • Сердце: Абсцесс Миокардит Перикардит Инфаркт • Нервная система: Абсцесс Менинго-энцефалит Киста • Сосуды: Васкулит Аневризма Тромбоз Геморрагии • Лёгкие: Абсцесс Пневмония Плеврит Инфаркт Эмпиема • Почки: Абсцесс Нефрит Инфаркт Острая почечная недостаточность • Печень: Абсцесс Гепатит Инфаркт • Селезёнка: Спленомегалия Абсцесс Инфаркт
Микробиологическая диагностика • 1. Микроскопический • 2. Бактериологический 3. Серологический
Микробиологическая диагностика • 1. Микроскопический • 2. Бактериологический 3. Серологический
 Микроскопический метод: • Цель: попытка • • обнаружения возбудителя Материал: гнойное содержимое Срок ответа: 2 -4 часа Используется при наличии у патогена характерных морфологических особенностей Мазки окрашивают и микроскопируют
Микроскопический метод: • Цель: попытка • • обнаружения возбудителя Материал: гнойное содержимое Срок ответа: 2 -4 часа Используется при наличии у патогена характерных морфологических особенностей Мазки окрашивают и микроскопируют
 Бактериологический метод: • Цель: выделение чистой культуры и ее идентификация • Материал: кровь, СМЖ, моча • Ход метода: МИ засевают на элективные питательные среды(КА, Сабуро) Чистая культура на 3 -4 сутки • Идентификация МО (МС, ТС, КС, Бх. С)
Бактериологический метод: • Цель: выделение чистой культуры и ее идентификация • Материал: кровь, СМЖ, моча • Ход метода: МИ засевают на элективные питательные среды(КА, Сабуро) Чистая культура на 3 -4 сутки • Идентификация МО (МС, ТС, КС, Бх. С)
 Методы выделения чистых культур бактерий • Изучение морфологических, тинкториальных, культуральных свойств чистой культуры. • Пересев чистой культуры на дифференциально-диагностические среды для изучения биохимических свойств. • Определение других свойств (антигенных, вирулентных), чувствительности к бактериофагам. • Определение чувствительности к антибиотикам.
Методы выделения чистых культур бактерий • Изучение морфологических, тинкториальных, культуральных свойств чистой культуры. • Пересев чистой культуры на дифференциально-диагностические среды для изучения биохимических свойств. • Определение других свойств (антигенных, вирулентных), чувствительности к бактериофагам. • Определение чувствительности к антибиотикам.
 Полимеразная цепная реакция (ПЦР): • Цель: обнаружение нуклеиновых кислот МО • Срок ответа: 2 часа • Наиболее эффективный метод!
Полимеразная цепная реакция (ПЦР): • Цель: обнаружение нуклеиновых кислот МО • Срок ответа: 2 часа • Наиболее эффективный метод!
 Серологический метод: • Цель: обнаружение Ат • Материал: сыворотка • ИФА, РМ, РСК и др.
Серологический метод: • Цель: обнаружение Ат • Материал: сыворотка • ИФА, РМ, РСК и др.
 • W. Osler (1885): «Имеется мало болезней, которые представляли бы больше трудности на пути диагностики, чем инфекционный эндокардит. Многие опытные врачи указывают, что почти у половины больных диагноз поставлен после смерти» .
• W. Osler (1885): «Имеется мало болезней, которые представляли бы больше трудности на пути диагностики, чем инфекционный эндокардит. Многие опытные врачи указывают, что почти у половины больных диагноз поставлен после смерти» .
 Спасибо за внимание!
Спасибо за внимание!


